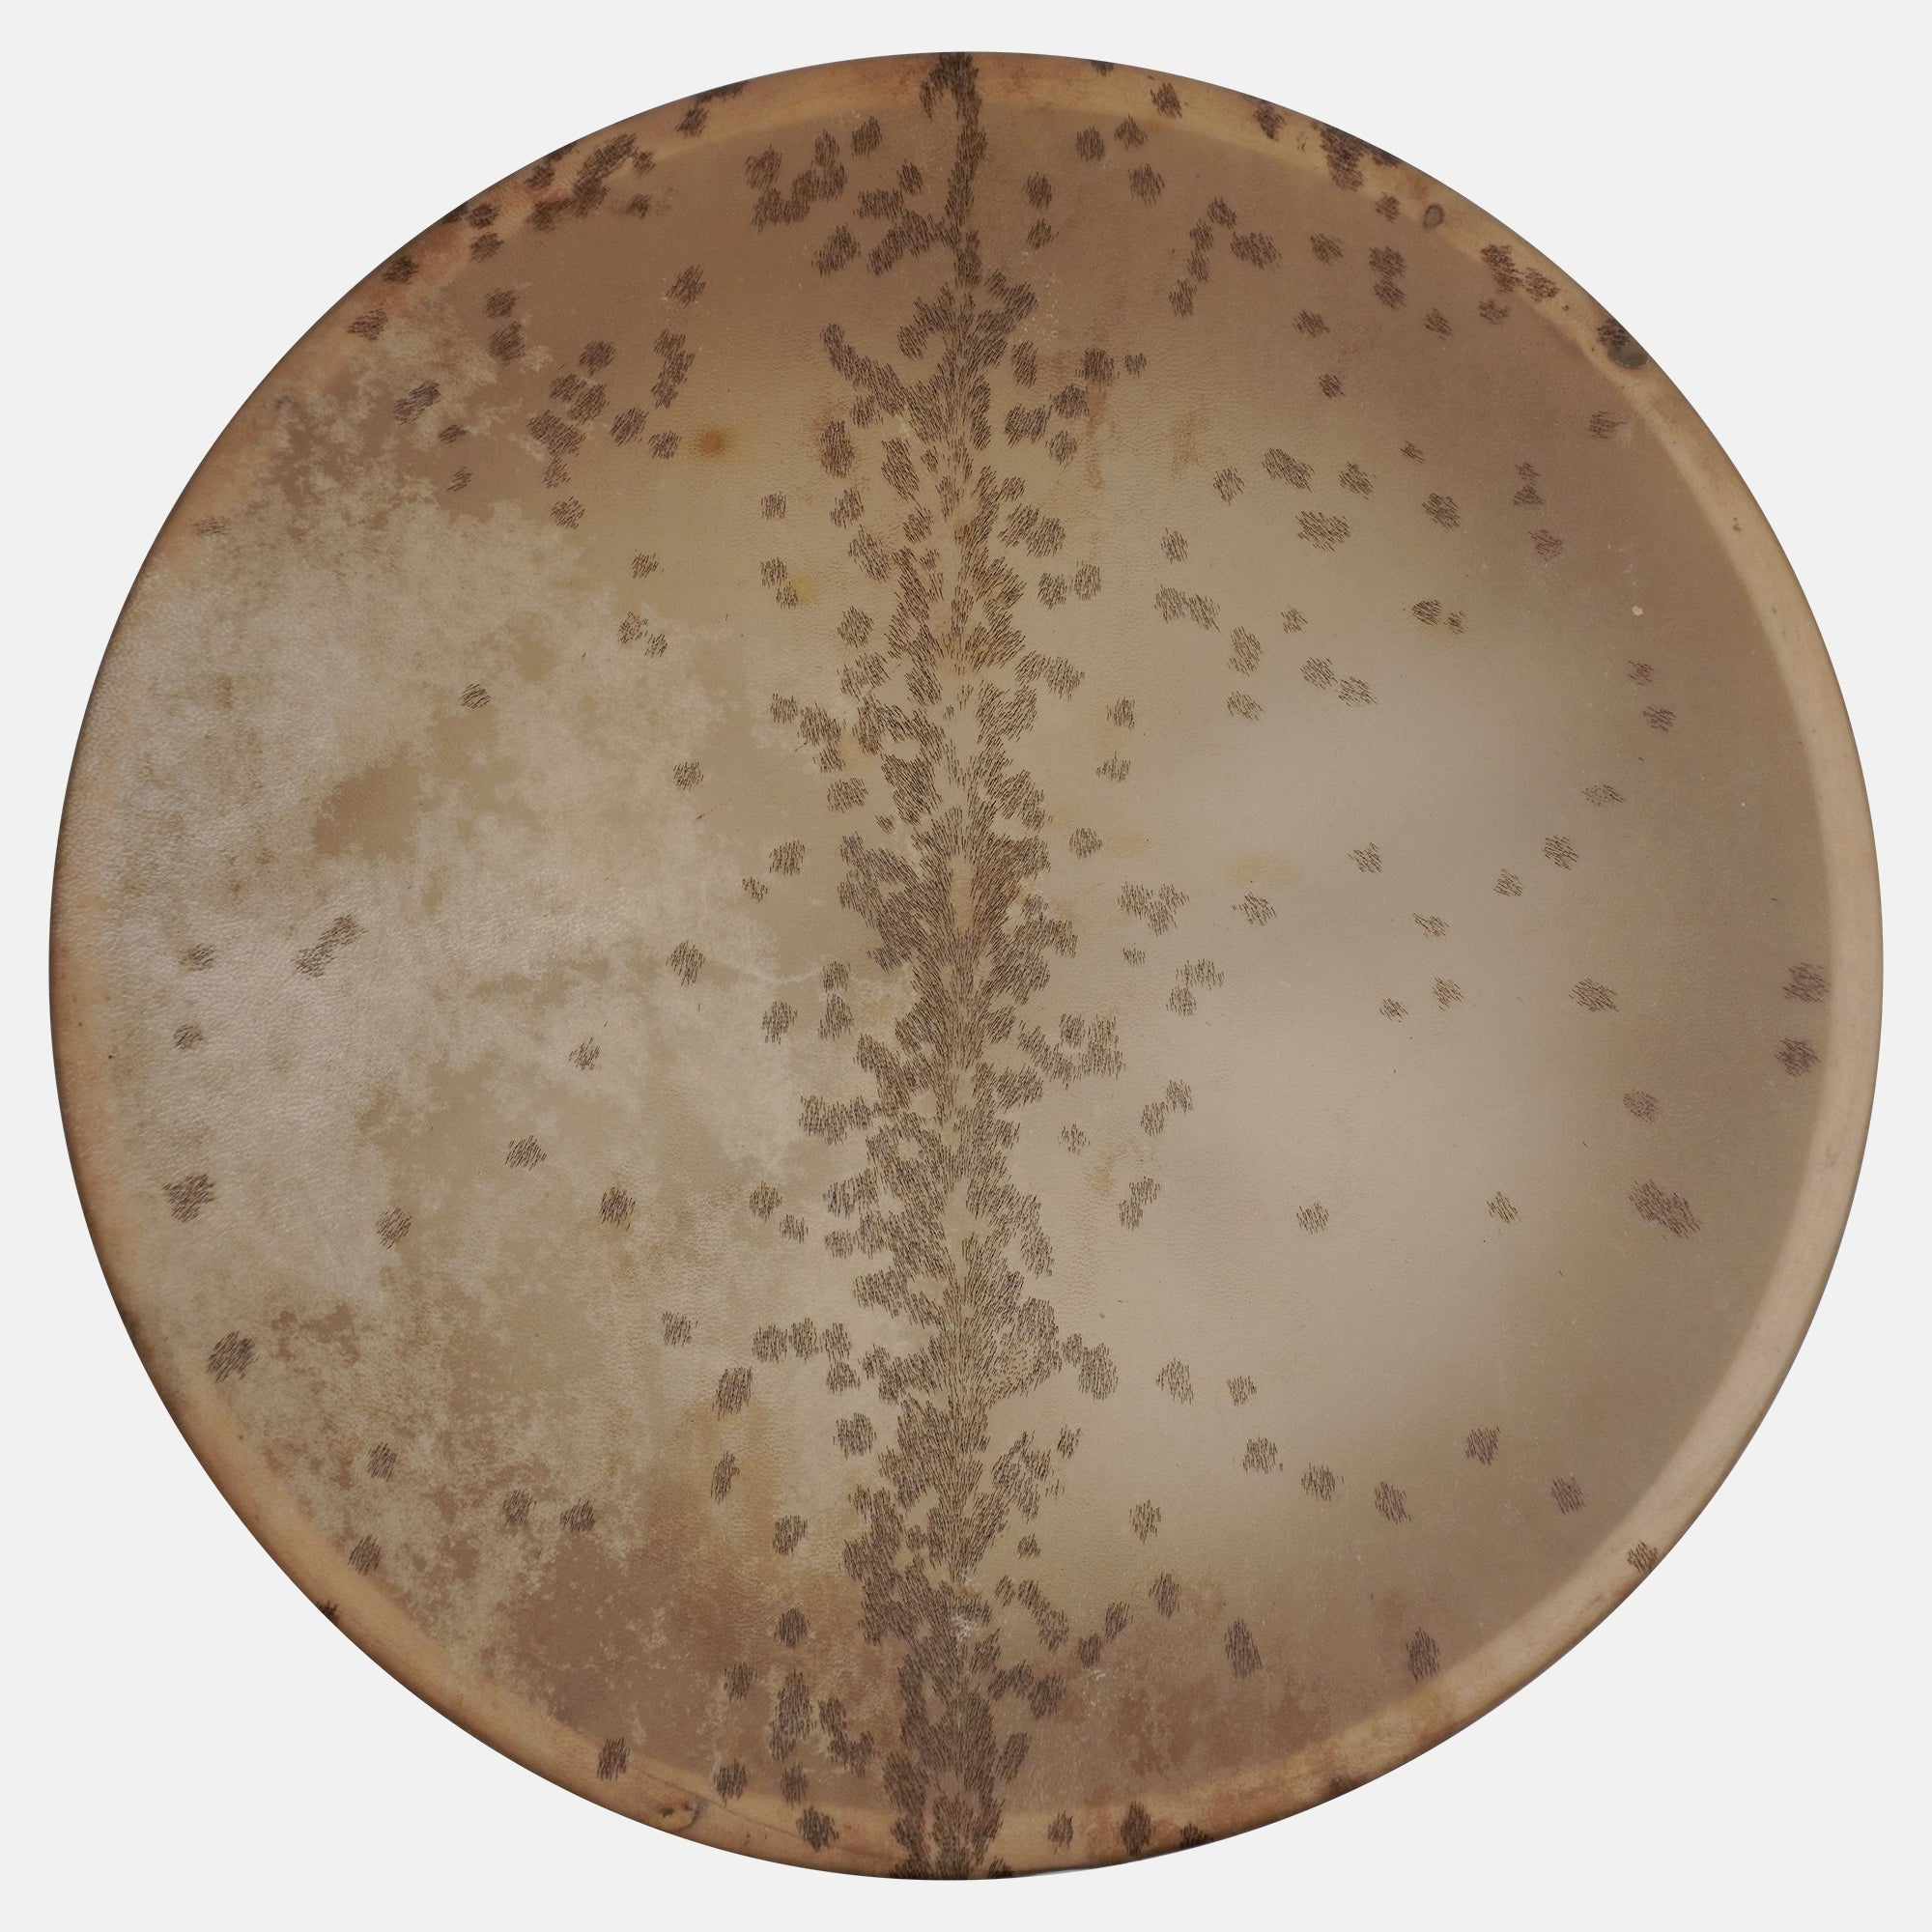

Schamanentrommel Medium, 35cm Ø Naturfell, inkl. Klöppel
Bereits hunderte begeisterte Kund*innen weltweit
- Erdiger, warmer Klang für dein Soundhealing
- Inklusive Klöppel
- Langlebiges Ziegenfell
- Jedes Instrument ein Unikat
Beschreibung
Diese imposante Schamanentrommel mit einem Durchmesser von 14 Zoll (ca. 35 cm) begeistert durch ihre authentische Ausstrahlung und das hochwertige Naturfell aus Ziegenhaut. Der passende Schlägel zu dieser imposanten Trommel ist inklusive. Dieses archaische Instrument ermöglicht dir ein faszinierendes, erdiges Klangerlebnis und lässt dich schamanische Rhythmen zum Leben erwecken. Genauso ist sie aber als Freehand Drum mit Händen und Fingern spielbar (z.B. auch auf einem Stativ). Es handelt sich um ein Naturprodukt, daher ist die Felloptik bei jedem Instrument einzigartig. Größen und Farben können geringfügig abweichen.
Begeisterte Bewertungen
Die Schamanentrommel, der weltweit vertraut wird
Kraftvoll im Klang, handverlesen in der Auswahl. Unsere Kund:innen weltweit lieben sie - für Rituale, Klangarbeit und Zeremonien. Percalada bringt dir den Unterschied.
★★★★★
Das sagen unsere Kund*innen

Authentisch, kraftvoll, transformativ
Über unsere Schamanentrommel
Unsere handgefertigte Schamanentrommel ist ein kraftvolles Werkzeug um Trancezustände zu induzieren und dich als das Medium auf deinen ekstatischen Reisen zu unterstützen.
Und das Beste für dich: Du bestellst sicher und ohne Risiko - mit 14 Tagen Rückgaberecht auf deine Bestellung. Sicherer Versand aus Deutschland.

Wo deine Schamanentrommel entsteht
Im Süden Indiens - in kleinen Werkstätten, fernab von Massenproduktion - entsteht deine handgemachte Rahmentrommel.Aus regionalem Weidenholz gefertigt, mit echtem Ziegenfell bespannt, wird jedes Instrument in stiller Hingabe gebaut.
Keine Industrieware. Sondern eine Schamanentrommel, die dich auf Klangreisen, Ritualen und in deiner Erdung begleitet.
Am Ende halten manche Trommelbauer kurz inne. Sie segnen das Instrument – mit einem Wunsch für den Menschen, der es später spielt.
Wenn du spürst, dass Klang mehr ist als Schwingung – beginnt deine Reise hier.
Du hast noch Fragen an uns?
In unserem FAQ Bereich findest du die Antworten.
Ganz klar - ja! Wir haben viele zufriedene Kundinnen und Kunden und möchten dass du glücklich bist. Sollte dir dein Artikel nicht gefallen, hast du dein 14-Tage-Rückgaberecht mit 100% Geld zurück Garantie.
Wir versenden mit DHL-GoGreen aus Deutschland. Innerhalb Deutschlands ist deine Bestellung in ein bis zwei Werktagen bei dir.
Für jedes handgefertigte Instrument, auch jede Schamenentrommel, gilt: Jedes ist einzigartig und klingt minimal anders. Bei der Auswahl suchen wir aber stets die Instrumente aus, die am besten klingen und bieten nur an was uns selber klanglich gefällt.
Wir verpacken alle Lieferungen so, dass das eigentlich nicht passiert. Sollte trotzdem beim Transport etwas beschädigt werden, melde dich bitte per Email oder telefonisch bei uns und wir finden eine Lösung.

DIE MISSION VON PERCAlaDA
Percalada bringt Musik in dein Leben
Mein Name ist Florian Bronk. Ich bin Musiker mit Leib und Seele. Mein Traum ist es, Schlaginstrumente sichtbarer zu machen und ihnen einen höheren Stellenwert zu geben. Ich wünsche mir, dass Menschen weltweit erkennen, welche unerschöpfliche Kraftquelle Klang sein kann, und dass mehr Menschen die heilende Kraft des Rhythmus für sich nutzen.